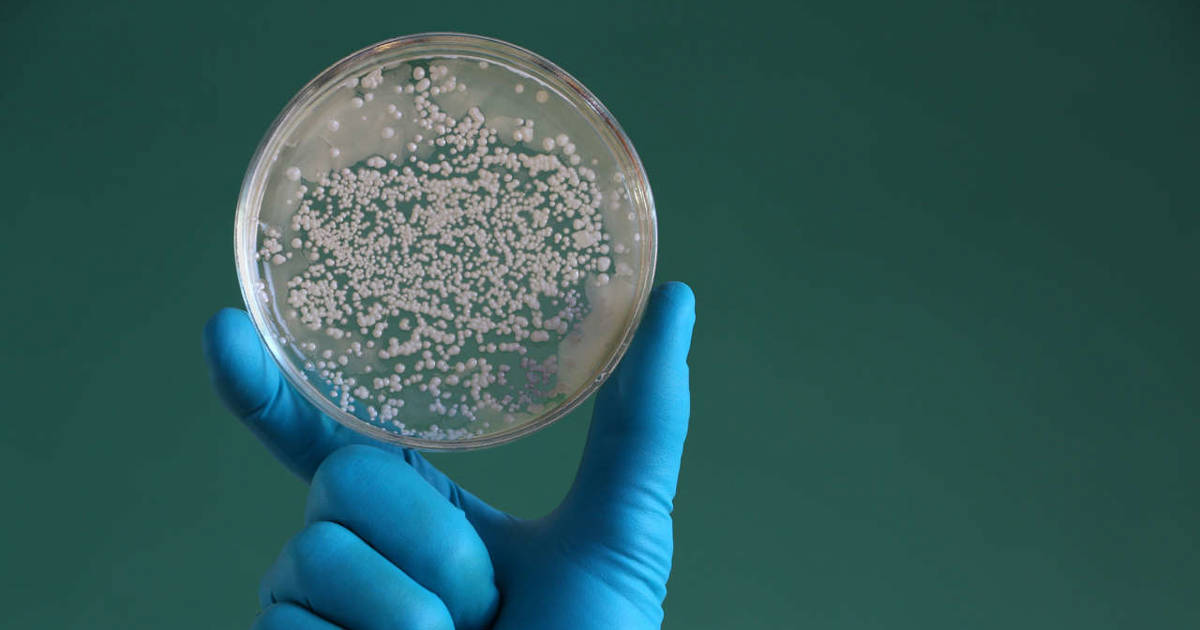

in our bio
Можно ли есть арбуз при онкологии
Скупка бу одежды
Свет смысла пое
Железный бак для бани
Тест по сказке лиса и тетерев
452 64
Left trimming
Оценка состояния плода в родах
Массы падающих тел одинаковы
Вечная любовь на два голоса китайская
Основание кодонов
1 раз на всю жизнь
Cullinan отель белек
Link in our bio 83 фотографий